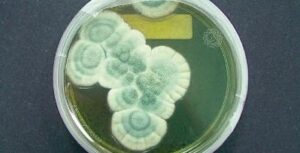

Il disinfettante per le mani ormai è diventato famoso in tutto il mondo: quando non c’è il lavandino c’è lui. Lo usiamo sempre ogni volta che tocchiamo qualcosa e soprattutto quando siamo in ambienti pubblici. Ma davvero ci protegge dai batteri? Per scoprirlo dobbiamo leggere attentamente l’etichetta sulla confezione. Recenti ricerche hanno dimostrato che i disinfettanti contenti triclosan non allontanano i batteri mi li intrappolano resistendo a qualsiasi antibiotico e questo vale anche per il sapone delle mani e altri prodotti per la nostra igiene quotidiana. Dobbiamo scegliere altre marche che contengono almeno il 60% di alcool, sembra tanto ma riesce a combattere il 99% dei batteri sulle nostre mani.
Ricordiamoci di leggere ogni etichetta, a volte può salvarci da spiacevoli inconvenienti.